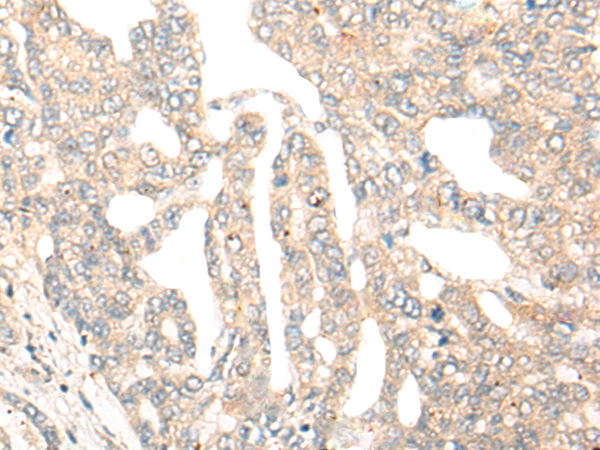

中文名稱: 兔抗DCP2多克隆抗體
|
Background: |
The protein encoded by this gene is a key component of an mRNA-decapping complex required for degradation of mRNAs, both in normal mRNA turnover, and in nonsense-mediated mRNA decay (NMD). It removes the 7-methyl guanine cap structure from mRNA, prior to its degradation from the 5' end. Alternatively spliced transcript variants encoding different isoforms have been noted for this gene. |
|
Applications: |
ELISA, IHC |
|
Name of antibody: |
DCP2 |
|
Immunogen: |
Fusion protein of human DCP2 |
|
Full name: |
decapping mRNA 2 |
|
Synonyms: |
NUDT20 |
|
SwissProt: |
Q8IU60 |
|
ELISA Recommended dilution: |
5000-10000 |
|
IHC positive control: |
Human thyroid cancer and Human esophagus cancer |
|
IHC Recommend dilution: |
25-100 |

購物車
購物車 幫助
幫助
 021-54845833/15800441009
021-54845833/15800441009
